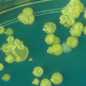
spot1

Cronobacter , which used to be called Enterobacter sakazakii , is a germ that can live in very dry places. Cronobacter has been found in dry foods, like powdered infant formula, powdered milk, herbal teas, and starches. It has also been found in sewer water. Cronobacter infections are often very serious for babies; they can die. Cronobacter infection can also be very serious for older people and people whose bodies have trouble fighting germs, like people with HIV, organ transplants, or cancer.
Spotlight
For Healthcare Providers and Public Health

Learn CDC’s role in food safety

Most people do not think about food safety until they or someone they know becomes infected with foodborne illness.
- Page last reviewed: July 18, 2017
- Page last updated: July 18, 2017
- Content source:


 ShareCompartir
ShareCompartir


